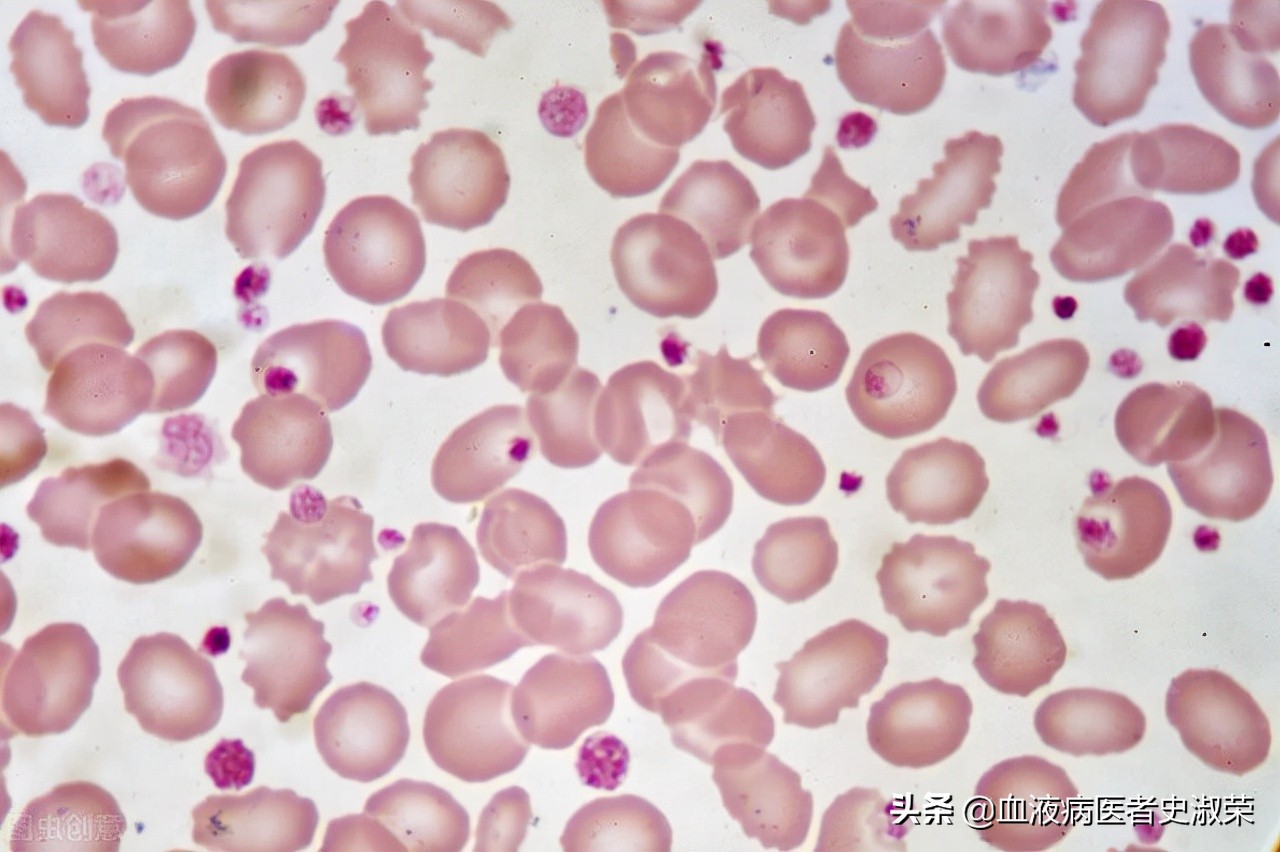
免疫性血小板减少停药会复发吗,血小板减少恢复5年了还会复发吗

血小板减少症是一种良性的血液病,但很多患者经过治疗缓解之后,还是会再次复发,这就使得患者的积极性容易被打击。那么,血小板减少症能治好吗?到底该怎么治疗才能稳定病情呢?
血小板减少症治疗过程虽然比较漫长,但只要坚持治疗,选择恰当的治疗方式,患者血小板数值可以恢复正常或者是维持在安全范围内,不影响正常生活。
那么西医临床上,治疗血小板减少症有什么方法呢?
1、激素治疗
首先一般先考虑药物治疗,如采用糖皮质激素、丙种球蛋白,这种治疗方法见效快,是临床最常见的方法。弊端主要是副作用会引起患者向心性肥胖,容易伤肝伤肾等等。
2、输注血小板
血小板减少症的临床表现为出血,轻微症状如口鼻出血,牙龈出血。进一步发展到消化道出血等,更有甚者会出现颅内出血危及生命。所以作为应急措施,一般采用输注血小板的方式,提高血小板计数来止血。

3、脾切除
血小板分布异常,在脾脏内滞留过多会导致肝硬化、脾肿大。进一步恶化会引发继发性脾功能亢进。因此部分患者会采取切脾的方法来缓解病情。
4、免疫*制剂抑**
这种方法多用于激素治疗无效的患者使用。可用药物如长春新碱、环磷酰胺和硫唑嘌呤等。
上述几种方法可以缓解血小板计数低的症状,达到提高血小板计数的目的,但疗效局限,有副作用大、易复发等弊端,面对这种情况,更多的患者会选择中西医结合治疗的方式。调整机体免疫机能的同时,缓解了西药带来的不良反应,提升治疗效果。
只有调节免疫增强免疫,解决造血病灶,促进骨髓造血,稳定提升血小板数值,才能避免病情复发。
关注我了解更多血液病知识。